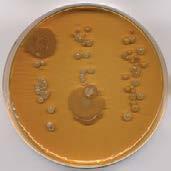

Times change. In the past, customers were grateful to be able to buy their food from their baker, butcher or farmer right next door, and conversely, farmers, butchers and bakers were satisfied if they were able to fulfil their customers' wishes. But the distance has increased both literally and figuratively. Insight and knowledge have been lost. Every small mistake becomes a scandal. Mistrust has spread, sometimes justified, but mostly unfounded.
Bread is no longer bread alone. It is only a good bread if it has been produced ecologically clean, baked with regional ingredients and – if ingredients from distant countries have been used – these have been harvested and processed under the best social and ecological conditions. The customer wants to have access to all the information, so it has to be provided.
Cumbersome? Maybe. Is that bad? No. The customer has always been King and he will remain King. Social media and various transparency requirements are his modern assistants. Influencers and even Greta Thunberg from Sweden are doing their job.
It would be unwise to try to resist this. The Generation Y, the digital natives, are changing society and thus the food industry. It sound’s a little silly that we are arguing about analogue data declaration (esp. nutri score) in the digital age. It will not be possible to keep it that way.

Only the readiness for transparency concerning raw materials, production and labelling will help food producers, bakers, butchers and farmers, and it will avoid further alienation between them and consumers.
We bake high quality bread for 500 million people in the EU every day. Vegan, vegetarian, regional, organic, with little salt, even without flour, or simply traditional. We are the experts! We can put the cards on the table!
Ours knows a good deal. Industry-specific processes, integration of machines and systems, monitoring and reporting, traceability, quality management and much more.



The CSB-System is the business software for the bread and bakery goods industry. The end-to-end solution encompasses ERP, FACTORY ERP and MES. And best-practice standards come as part of the package.

Would you like to know exactly why industry leaders count on CSB?




PUBLISHING COMPANY
f2m food multimedia gmbh Ehrenbergstr. 33
22767 Hamburg, Germany
+49 40 39 90 12 27 www.foodmultimedia.de
PUBLISHER
Hildegard M. Keil
+49 40 380 94 82 keil@foodmultimedia.de
EDITOR-IN-CHIEF
Bastian Borchfeld
+49 40 39 90 12 28 borchfeld@foodmultimedia.de
EDITORIAL STAFF
Helga Baumfalk +49 40 39 60 30 61 baumfalk@foodmultimedia.de
Katrina Finley finley@foodmultimedia.de
ADVERTISING DEPT.
International sales director
Dirk Dixon +44 14 35 87 20 09 dixon@foodmultimedia.de
Advertisement administration
Wilfried Krause +49 40 38 61 67 94 krause@foodmultimedia.de
DISTRIBUTION
+49 40 39 90 12 27 vertrieb@foodmultimedia.de

TRANSLATION
Skript Fachübersetzungen Gerd Röser info@skript-translations.de

TYPESETTING
LANDMAGD in der Heide Linda Langhagen; design@landmagd.de
PRINTED BY
Leinebergland Druck GmbH & Co. KG Industriestr. 2a, 31061 Alfeld (Leine), Germany
BAKING+BISCUIT INTERNATIONAL is published six times a year. Single copies may be purchased for EUR 15.– per copy. Subscription rates are EUR 75.– for one year. Students (with valid certification of student status) will pay EUR 40.– (all rates including postage and handling, but without VAT).

Cancellation of subscription must be presented three month prior to the end of the subscription period in writing to the publishing company. Address subscriptions to the above stated distribution department. No claims will be accepted for not received or lost copies due to reasons being outside the responsibility of the publishing company. This magazine, including all articles and illustrations, is copyright protected. Any utilization beyond the tight limit set by the copyright act is subject to the publisher’s approval.
Online dispute resolution in accordance with Article 14 Para. 1 of the ODR-VO (European Online Dispute Resolution Regulation): The European Commission provides a platform for Online Dispute Resolution (OS), which you can find at http://ec.europa.eu/consumers/odr
Valid advertising price list: 2019



In the past, artisan and industrial operators in the Slovakian bakery sector were organized into four different associations. On the initiative of a few major companies, all have now combined to form a single federation. We talked to Ing. Vladislav
Slovakia, who helped initiate this development.
+bbi: Mr. Baričák, as CEO of Penam Slovakia, you manage one of the biggest bakery companies in the Republic of Slovakia where, on your initiative in particular, you have just combined four previous associations into a single federation. There are between 450 and 500 bakery businesses in the Slovakian Republic, so why were there four associations in the first place, and what were the differences between them?
+ Baričák: The origin must be sought in history when there was even more bakery in Slovakia than it is today. The bakers were also joined by confectioners and pasta producers, or bakeries were also focused at the same time on confectionery production. Consequently, companies were more associated with the region, as they "had the closest to each other". That is why, for example, the Guild of Bakers and Confectioners of Eastern Slovakia and the Guild of Bakers and Confectioners of Western Slovakia were established in Slovakia. The youngest organization that was established in 2015 is the Union of Industrial Bakers of the Slovak Republic, which aimed to bring together the largest industrial bakeries in Slovakia. However, the oldest association on our territory was and still is the Slovak Union of Bakers, Confectioners and pasta producers. The fragmentation of bakers in different organizations was probably also related to the fact that we ceased to be aware of coherence and did not think that a unified organization could solve the problems of our sector comprehensively – ie. solve the problems of small, medium and large bakers. But over time, history has been right and if we are united, we can do more together. That is why we have begun to fight for a really strong organization to represent the vast majority of bakers in Slovakia. We started a recruitment campaign in the oldest association – the Slovak Association of Bakers, Confectioners and Pasta producers, and it was successful. In the past and this year, the vast majority of bakers who have been working in other professional organizations, or none at all, have become members of the association. While, for example, in 2018 the Slovak Union defended the interests of bakery companies with 5,000 employees, this year it will be 2,000 more people. This means that the unified organization of the Slovak Association of Bakers, Confectioners and pasta producers will represent 7,000 employees in the sector out of a total of 11,000. The remaining 3 professional organizations have also joined the Slovak Association of Bakers, Confectioners and pasta producers as collective members.
+ bbi: To allow the situation regarding baked products manufacturers in Slovakia to be put into perspective – could
, CEO of

you please give us a brief overview of how many companies produce on an industrial scale and how many large and small artisan businesses there are, and what proportion of the sale of baked goods in Slovakia is in the hands of the food retail?
+ Baričák: As the Statistical Office of the Slovak Republic does not have all the operations in the bakery and confectionery sector, the data on the number of companies are only a professional estimate. There are approximately 500 bakery and confectionery production facilities in Slovakia. Large industrial bakeries are about 30, while these supply about 60% of the market. The remaining 40% of the market is supplied by large and small craft businesses, but they also have machinery technology to increase production process automation. At the same time, the share of these domestic producers in the grocery stores is estimated at 60%, while the remaining 40% is imported from neighboring countries, and this negative trend continues and is increasing. To
The core of the problem in the Slovakian baked products market is the market power of foreign retail groups like Tesco, Lidl, Billa and Kaufland, whose combined market share and thus purchasing power is estimated to be 45%, whereas smaller domestic retail groups with considerably more locations amount to a total of 30%, and artisans and regional chain stores account for the remaining 25% share of the baked goods market.
Like in Austria, many artisans and chain store operators also supply the retail at the same time. Price-sensitive key articles on the baked products shelf, like a 1 kg mixed
illustrate: 10 years ago, about 90% of domestic bakery and pastry products were on Slovak bars and 10% were imported.
+ bbi: What are the most important problems facing baked products manufacturers, what aims is the new federation pursuing, how does it plan to achieve these aims?
+ Baričák: There are several problems. The key is that the traditional bakery is gradually losing its value, and that is why many bakeries disappear. It is also related to the fact that the economic power of a nation is not strong enough and, as a result, local patriotism is not developed in Slovaks, such as in Germans or Austrians. Still the main factor in our choice remains the price, and foreign trade chains have built their policy, not just in our country. In the last ten years, when the chains were very strong in our country, bakers have begun to lose a lot of money. The dominant strength of foreign merchants caused them to have the power to push suppliers, in our case of bakers, at such low economic prices, which in many cases do not even cover production costs. And bakers often attempted to save and maintain large volumes of sales. This led us to significant economic difficulties, when several bakeries were forced to close, some bakeries were sold, others ended up in red. The aim of the association of companies in the Slovak Association of Bakers, Confectioners and Pasta producers is to be a joint effort to correct the covered market or to fight for better and enforceable legislative conditions contained in the laws. Recently, we have succeeded in changing the law on the law on prices (it should apply from the beginning of May 2019) or inadequate business conditions to help foreign networks not apply their predatory pricing
+ bbi: The Slovakian government has just adopted a legislative package designed to limit the market power of the big trading groups. In your opinion, which aspects of this package are likely to have positive effects for baked goods producers?
+ Baričák: I have to say that bakers appreciate the amendment of two key laws - the Unfair Commercial Terms and Prices Act. While the first one sets a number of positive changes, such as shortening the maturity of 15 days invoices, eliminating hidden fees, which often reduce the profits of bakers, tightening
wheat bread (70:30) or the the typical rolls rožky (in Czech language rohlíky), are frequently sold as customer magnets for 1 Euro and less than 5 Euro cents respectively. Persistent overcapacity is another of the reasons. Insiders estimate an overcapacity of 40% for rožky (rohlíky) alone.
The Slovakian government introduced a series of legislative initiatives in late 2018 and early 2019, partly already implemented and partly got underway. The aim is to reduce the dominance of big retail groups, mostly foreign, on the Slovakian food market, and to open up more opportunities for other players in the market.
controls on vendors, whether the customer can request a reduction in the purchase price from the supplier only if goods are actually sold to consumers in the stock price. Of course, the most positive in it is the sale ban below economically justifiable costs (production costs), ie. the customer will not be able to demand the sale of the products below the cost of production of the supplier, which is a common practice in business relations in the long term. On the contrary, the second amendment to the Act – the Act on Prices – stipulates that the determination of economically justifiable costs will be the responsibility of the Ministry of Agriculture and Rural Development of the Slovak Republic as an independent body, while the law requires regular updating of economically justifiable costs for the current situation.
+ bbi: Mass market products such as wheat mixed bread or rožky (rohlíky) are a serious problem in the Slovakian baked goods industry. The food retail offers them as loss leaders at extremely low prices. According to our information, a law is being prepared to limit the retail trade’s margin and to ban purchases below production costs. Do you hope this will ease the price pressure on manufacturers in the mass market products business?
+ Baričák: We believe in it. The price of a traditional white roll has not changed in Slovakia for years, the price of a classic 1-kilo bread has even dropped, but there is no economic reason for it. The price of raw materials and the price of labor for the last grew rapidly. For comparison only, the price of flour increased by 20-30% in the last year, the price of poppy increased by 102%, potato flour by 34%, salt by 64%, greaves by 101%, energy by 20%, but also the price of fuel substances. However, the largest item was fast-growing salaries, where average wages climbed by almost 10 percent.
+ bbi: A few weeks ago, the government significantly increased extra pay for night-time and public holiday working. However, bread factories cannot operate without night-time and public holiday working. How will the wage increases affect you?
+ Baričák: Significantly. According to statistics, up to 80% of the working time of bakers is burdened with extra charges
for weekend work, public holidays, and night work, known as the government's social package, and the Slovak bakers are most likely to pay for it. The first wave of social package started in May 2018, the second wave of the social package will start this May, which means that surcharges will increase again from last year's wages and will be deducted from the minimum wage. It has also increased since the new year (from EUR 480 in 2018 to EUR 520 in 2019). Wages currently account for an average of up to 38% of total production costs. While in 2017 the average monthly wage was 677 euros, in 2018 it was 731 euros, an increase of almost 10%. In May of this year, the second wave of the social package, which will represent a further rise in labor costs, will come into force, with wages exceeding 40% of total production costs.

+ bbi: The association’s tasks also include targeted public relations work in the country. What exactly do you do, and what effect do you hope you will have?
+ Baričák: Yes. In March of this year, the Slovak Association of Bakers, Confectioners and Pasta producers distributed the Fair Trade Award. It was acquired by those traders who adhere to fair trade relations and do not push suppliers to disproportionately low prices, which are predominantly focused on selling Slovak products or those who do not work with hidden fees, often at the expense of suppliers. This year, Labaš, p. r. o., MILK-AGRO, s.r.o., CBA Slovakia Lučenec, a.s., Makos, a.s., DEKORT, s.r.o., COOP Jednota Slovakia and CBA Slovakia, a.s. The award was given to the companies by the Deputy Prime Minister and Minister of Agriculture and Rural Development of the Slovak Republic, Gabriela Matečná, at the historically largest General Assembly of the Slovak Association of Bakers, Confectioners and pasta producers. We want to pass this award every year, and we want to show it to consumers and educate them a bit about how Slovak food goes to the shop shelves and what process it is. At the same time, the Fair Trade initiative aims to show the public who is fair to their suppliers and is willing to bear the risks stemming from the rise in raw material prices and other inputs, on the basis of which bakers objectively ask for higher sales prices. In addition to this initiative, we have been intensively communicating our visions, problems and the state of the sector for three years, as well as plans for the future for the media. Through them we try to move our link to lay and professional
public, what we are doing. At the same time, we organized a joint exhibition – Bakery Court – at the biggest gastronomic event for the general and professional public Danubius Gastro, where visitors could learn about products based on Slovak bakeries and news that they are just preparing (eg. Loin bread).
+ bbi: Have the country’s politicians already responded to the new federation?
+ Baričák: Certainly resonated. In the media, we regularly communicate the steps of the government that we do not like, as well as those for which we are grateful to help us. We are certainly also more active in communication with the agricultural sector or the Slovak Government and have a stronger voice, thanks to the wide representation of bakers in the association.
At the same time, the agricultural sector has begun to notice our struggle to save the industry and stand by us eg. at the Fair Trade Initiative. We again have to admit that we appreciate the ministry's activities in fighting for domestic products and promoting local patriotism.
+ bbi: Will this new federation collaborate with other national associations at a European level, or does such collaboration already exist?
+ Baričák: European bakers' cooperation has already begun last year. In the summer of 2018, we signed a Memorandum of Fair Trade on the Slovak level with representatives of the Trade Union of the Slovak Republic (which brings together Slovak retailers), on the basis of which the Fair Trade initiative was created. In autumn 2018, we also signed a Memorandum of Cooperation in the Bakery Industry in Munich together with other bakery organizations from the Czech Republic, Hungary, Poland and Romania. Our common goal is to fight for better conditions for bakers in the market, to fight against predatory pricing of foreign chains and to exchange information on steps that have a positive or negative impact on the bakery sector. This memorandum was signed in the presence of Antonio Aries from Mexico, President of the World Union of Bakers and Confectioners UIBC (International Union of Bakers and Confectioners) and Fernandez Villaverde of Spain, General Secretary of UIBC.
+ bbi: Mr. Baričák, thank you for the discussion. +++

with this master baker mindset, like our modular AMF Den Boer Tunnel Ovens, which allow us to engineer the most optimal baking solutions for today while preparing your bakery for future growth.


G et in touch with the industry ’s only tr uly g lobal complete system supplier for the best unit equipment and integ rated solutions for your operation. Booth 5436/5420

+T he Lesaffre yeast group has established a Baking Center in the Vienna-Neudorf industrial zone on the southern outskirts of the Austrian capital city. The bakery, laboratory and training facilities complex covering more than 600 m2 is aimed primarily at industrial and major artisan customers in western and eastern Europe. In addition to mixers and a sourdough preparation unit available for trials and product development, there is also a selection comprising a Rondo dough sheeting line, a König line for bread rolls, buns and donuts, and a Rheon stress-free V4. Proofing, baking and freezing take place in a Miwe plant combination. In addition there is a Rheon Cornucopia, and a Riehle fat-frying line stands ready for tests with fat-fried products. A small laboratory is also available for raw materials and quality investigations.


Lesaffre produces not only yeast for the baking sector but also sourdough, baking agents and premixes. Mixes and premixes, e.g. a protein bread mix, are marketed under the Inventis brand. The Group sells a full range of baking agents under the Magimix name for both fresh and frozen products, wheat and rye doughs, and aimed at specific dough problems. The third brand name in this product range is Levendo. Behind this lie sourdoughs arranged according to flavor profiles, including a liquid sourdough with live microorganisms that promises a “French flavor note” in the finished baked product. +++
For SIL (Société Industrielle Lesaffre), the Vienna site is centrally important to the European business. In 1996 the French took over the yeast business from Mautner-Markhof, the Austrian yeast mogul at that time, which not only dominated the Austrian market but had also bought up yeast factories in the former k.u.k. (Austro-Hungarian Imperial) countries immediately after German reunification. Lesaffre has operated the world’s biggest yeast factory at the company’s headquarters in Marcq-en-Barœul since 1968. The Budapest yeast factory from the M(autner)-M(arkhof) empire has grown into an important supplier to European markets. Yeast is also produced in Poland, Croatia, Romania and the Czech Republic, and at three locations in Russia. The Group owns the Asmussen GmbH production facility in Elmshorn in Germany.
Lesaffre Germany serves the German market through Fala GmbH based in Kehl am Rhein. Lesaffre Austria currently has 45 employees on its payroll, whose responsibilities include domestic business and the baking agent division’s exports. Yeast is marketed in Austria mainly through Bäko.


According to CEO Antoine Baule, the yeast market is growing worldwide. He says this is currently especially noticeable in Asian, Latin-American and African markets. A middle class with an increasing demand for bread and thus a need for yeast is coming into existence in these countries. In Europa, according to Baule, demand growth is mainly in sales of liquid yeast, whose metering can be integrated into automated processes. Lesaffre offers it in various types of package, starting with a bag-in-box system and mobile containers for artisan bakeries, and extending to large containers or tanker trucks for major consumers. +++


The Lesaffre Group is the world’s biggest yeast supplier. The company’s headquarters is in Marcq-enBarœul, a small town in the northeast of France close to the Belgian border. The Group, which originates from an alcohol distillery founded in 1853, has a current worldwide turnover of more than EUR 2 billion, 70% of it through business with baked products manufacturers in the form of yeast, sourdough, mixes and baking agents. The remaining 30% is contributed by three business divisions, all more or less based on fermentation technology. HealthCare focuses on healthpromoting products for use in the care of people, animals and plants (companies: LHC, Phileo and Agrauine). Antoine Baule, CEO of the Lesaffre Gruppe, says: “We don’t want to leave this area to the pharmaceutical industry.” A second division is devoted to industrial biotechnology, including for bioethanol and animal feed manufacture (companies: Leaf and Procelys). The LIS company, which also belongs to this Division, specializes in spray-drying as a service. A division known collectively as “Food Taste and Pleasure” deals with fermentation products that improve the flavors of wine and beer (Fermentis), food flavorings such as vanillin (Ennolys) or yeast extracts and natural flavorings that allow salt and sugar contents to be reduced (Biospringer).
The company operates 60 production facilities in more than 50 countries worldwide, whose products in turn go to customers in 185 countries. The total worldwide workforce is around 10,500 employees. Applications research for the various business areas takes place in 56 subsi-diaries. Baking Centers are located at 44 sites, including Vienna, where demonstrations to customers, tests and product development for baking sector customers can take place. +++

The Menes dough sheeting line can process up to 5,000 kg of dough. The line can be adapted to your needs with its elaborate modular design and is also available in hygienic design „H“ as wash-down version. The Menes line combines high weight accuracy with perfect handicraft quality.

DESIGN “H”
We set our focus on your product!ROTARY MOULDER
Spooner Vicars (part of the Middleby Group) has launched a new rotary moulder. The APEX Sport can handle a wide range of doughs, from detailed surface designs to deep-moulded shortcakes with fruit inclusions. The newest design focuses primarily on hygienic design.

+The company eliminated machine threads wherever possible and gave ample clearance under the machine for cleaning. Using direct drive motors allows the removal of many guards, as there are no transmission pieces such as chains and belt, thus allowing easy access for cleaning. The machine has three drive motors, allowing individual adjustment for the feed roll, die roll and belt.
+ Powered Feed roll: this allows the roll to be speeded up or slowed down, allowing precise filling of the die cavity

+ Powered die roller: this will be set to match the linear speed of the oven belt
+ Powered product belt. Dan Christie, Sales Manager Spooner Vicars, explains: “With many rotary moulders, the product belt is clutch-driven between the die roller and rubber roller. This is fine until the belt slips and then you apply more rubber roll pressure which creates product tails. When it is on its own drive, you can back off the rubber roll pressure and still drive the belt.”
According to the company, the die drive does not require a gear, which brings the total cost of buying dies down and
makes product changes fast. Dan Christie: “The machine comes with a belt tracker as standard, whereas with many manufacturers this is an option.” The feed roll has an adjustable gap for different dough viscosities. This gap is the distance between the feed and die rolls. The gap adjustment along with the knife adjustment can be manual or motor driven for settable recipe control, as the machine also comes with PLC controls.
Dough is put into the machine hopper, which sits on the top over the feed and die roller. The die roller rotates clockwise and the feed roller counterclockwise, allowing product to be pushed into the die engravings (cookie shapes). A knife which runs along the entire width of the die scrapes off any excess dough. At this point the belt contacts the surface of the die and the rubber roll slightly presses the dough (cookies) unto the belt surface. The belt then pulls the product out of the die roller and transfers it to an oven belt for baking. +++




The Italian baked products manufacturer Galbusera’s new production facility is taking the first steps towards Industry 4.0. Oripan, an IT company partly owned by Sancassiano, is also involved.
+A 16,000 m 2 production area south of Milan came into operation last fall. It was planned and implemented by the Italian baked products manufacturer Galbusera, which moved in the new site its production of cakes and seasonal products like panettone and Easter dove cakes from the previous site in downtown Milan. The line for panettone and dove cakes is entirely new, and the cakes line is also new, except for the oven. A third new line for a novel product is just entering the production phase, and a fourth for crackers is currently being built.
Enterprise Resource Planning (ERP)
However, the reason for the new production center was not only to increase production through more capacity and new production lines, but also the decision to take a clear step towards automation and digitization. Support for the project came from the new state funding program for Industry 4.0. The old factory already had a raw materials traceability system. According to Dante Gelmini, Head of IT, the aim here was and still is to gain more information about the detailed status of the process chain, thus raising efficiency. As an example, he illustrated some details of line Line 1, which
This controls and administers operational resources, e.g. capital, personnel or means of production, in the best possible way based on a standardized data base, and the system usually comprises materials management, sales and marketing, finance and accountancy, controlling, human resources, the management of product data, historical files, documents and an interface to production and production planning.
Manufacturing Execution System (MES)
A multi-layer fabrication management system that thinks in process chains and translates production requirements from the ERP system into the most efficient possible production planning, collects and records production, machine and operating data, and enables real-time fabrication control.
Oripan Factory System (OFS)

Undertakes communications and creates the instructions to tell machines what is to be produced, in which amounts, when and in which process chain. The starting point for the OFS is the number of SKUs (stock-keeping units = distinctly identifiable articles; article variants have different SKUs) that are to be produced. It then decides the number of batches and calculates the time up to the packaging stage.
Maschinen (PLC)
Controlling individual machines and plants.
produces panettone from September to December and Easter dove cakes from January to May: Breaking the production program down by process parameters and recipes, 20 different varieties and 300 different SKUs (Stock-Keeping Units) must flow through the production line efficiently and trouble-free 24/7 during this period.


As the digitization partner, Gelmini brought on board Oripan, an IT company in Tione di Trento in which the mixer manufacturer Sancassiano in Roddi holds shares. The Piedmontese company brought in many years of process and machine knowledge, and its supervisor is responsible for the central dough preparation plant that supplies dough to all the lines. The line consists of two linear Robomixers together with metering stations for automatic loading and manual addition. There are integrated dough resting stations in which panettone doughs, for example, rest twice for up to 7.5 hours before going onto the line after a final kneading. With few exceptions, all the other plants are from Italian machine builders, and many production steps such as surface scoring, stacking flat baked products or packaging are carried out by robots. A total of 130 employees now work in the factory, 100 of them in a three-shift production operation.
Production planning starts with the Manufacturing Execution System (MES), which translates the production requirements from the ERP system into the most efficient possible

Italy has launched a program to promote investments that enable or speed up the automation and digitization of production processes. The national plan, “Industria 4.0”, was presented in 2016 and has provision for massive tax concessions together with numerous measures such as investments in education and training. In addition, each region is implementing its own individual broad program of incentive measures. This program has not only resulted in a considerable increase in the number of startups. In the first half of 2017, investments in machinery rose by 11.5%, in electronics by 10.7% and in research & development by 15%. In addition, Italy reduced the corporation tax rate from 27.4% to 24% in 2016.
The tax law has numerous other motivations. For example, the return on investment for certain investments up to a maximum of EUR 150,000 can be made tax-exempt for five years. There are tax credits for R&D activities, special depreciations on patents, and income tax concessions for highly-qualified people to attract them into the country.
Something that will probably make life particularly easy for Italian companies is the Finance Ministry’s plan to structure its administration in such a way that companies will now have only one contact point for both their tax liability and the subsidies.
production planning. The MES in turn sends its requirements to the Oripan Factory System, OFS, which undertakes the detailed planning.
The starting point for the OFS is the number of SKUs (stock-keeping units = distinctly identifiable articles; article variants have different SKUs) that are to be produced. It then decides the number of batches and calculates the time up to the packaging stage. To avoid congestion on the line, the supervisor plans all the processes, calculating the start of each operation backwards from the packaging phase to the raw material metering and mixing time. The algorithm optimizes the size and sequence of batches and the overlaps that may occur between them such that no collisions arise upstream the oven entry, ensuring no idling on the other hand. To this end, the first step is to verify whether all the raw materials are available and the individual stations on the line are free at the required time. Furthermore, the supervisor also checks whether the time needed to heat up the oven, or to let it cool down when necessary, was included in the calculation.
OFS synchronizes each process step with the MES and feedbacks the material consumptions for traceability and reordering purposes. It also includes raw materials warehouse supervision. The OFS correlates raw material warehouse outflow with the perspective production batches.
If people intervene in the production flow, e.g. by manually adding raw materials or giving a signal, the OFS requires confirmation by scanning barcodes on the transport containers and addition point.

The purpose of what has been installed up to now is communication and information gathering to optimize production planning. Direct interventions in individual machine controllers are reserved for subsequent further developments of the system. As the next project, Gelmini initially plans to incorporate servicing and maintenance, including preventive actions, into the factory digitization. The aim of this is to allow the company’s own technicians to immerse themselves in virtual reality, thus enabling them to remedy malfunctions based on embedded handling instructions and/or with digital support from suppliers’ technicians. Gelmini says: “We hope that will result in significantly fewer downtimes on the lines.” +++
The Italian family business was founded by Ermete Galbusera in 1930 as a cookie manufacturer in Morbegno and built up to national importance by his sons Mario and Enea Galbusera. It produces wafers, cookies and crackers on eight lines at the company’s present headquarters in Cosio Valtellino under both the Galbusera and Tre Marie owned brands, including also several private labels. A production factory opened in Vellezzo Bellini last year, producing cakes, gateaux, panettone at Christmas and colombas (dove cakes) at Easter in many variations. www.galbusera.it
The Tre Marie is an historic and well-known brand in Italy, deeply rooted in the panettone and colombas markets. The previous owner, The Sammontana S.p.A., an ice cream and frozen products maker, expanded the product range to include frozen pastries such as filled croissants and cannoli. In 2013, Tre Marie was acquired by Galbusera, which carries the production of panettone, dove cakes, cookies and gateaux. Frozen pastries are yet produced by Sammontana, but the commercialization is still managed under the Tre Marie brand.
Oripan is an Italian IT company dealing with networking complex production processes in the food industry. By using OFS (Oripan Factory System), a manufacturing execution system to plan production and automate the flow of information along the production chain in real time, Oripan lays the foundation for the process prescribed by Industry 4.0. The business is a Microsoft Partner supplying software together with selected hardware, and supports applications in Europe, Asia and North America. Oripan is a 30 years experienced company in automation and digitalization of the industrial bakeries and in 2015 become part of Sancassiano group. Oripan’s headquarters and ICT division is in Tione di Trento. The Industrial Automation division works at Sancassiano’s corporate head office in Roddi. www.oripan.it
++ Every raw material is precisely encoded as received and after quality testing, thus enabling its quantity, storage and date/time to be accurately traced. When materials are withdrawn, the codes are scanned and linked to the code of the dough batch currently running, together with a record of the date/time, quantity and addition valve identification

What drives the Clean Label movement? How does this affect artisan bakers? We talked to Michel Suas , President and Founder of the San Francisco Baking Institute, about Clean Label in the USA.

+bbi: Recently, you gave a seminar on Clean Label artisan bread in Texas. Unfortunately, we were unable to attend, but we would like to learn more about the clean labeling presentation.
+ Suas: The seminar’s focus was on the baking movement over the past 30 years in the USA and other countries. The artisan bread movement started around 1986 and the trend hasn’t stopped and has become an art for the consumer, incorporating diet selection and quality bread without additives. Clean Label was already in place at that time for small and mid-size bakeries
+ bbi: What is a “Clean Label”?
+ Suas: Initially, Clean Label was only the ingredients used for the actual bread formula: flour, water, salt, commercial yeast, or wild yeast, and excluded emulsion components, shelf life extension, or stabilizers that most of the large bakeries were using to make bread with at that time.
+ bbi: What ingredients are considered Clean Label?
+ Suas: Clean Label is not organic; it just includes conventional ingredients with no chemicals added during bread production. Now Clean Label is all about what the baking industry as a whole has been doing over the past few years and also looking ahead, what it will be doing. All the additional ingredients added to the basic formula are made with natural components, with enzymes predominantly used for these purposes.
+ bbi: How does the “Clean Label” movement affect the baking industry?
+ Suas: Again, we are talking about the large-scale distribution for store chains, institutions, and hotels. The new approach to manufacturing bread or any mass-produced food with Clean Label starts with the consumer who is looking for better, healthier food. Consumers are starting to read the label more and more and are also exposed to smaller production bakeries. The customer is now educated about the taste difference. U.S. customers are now looking for better food, as part of their lifestyles, and even large chains such as McDonalds are trying to portray a different image to the public.
+ bbi: What do you think is driving the Clean Label movement?
+ Suas: The continued drive for Clean Label or better food is multi-area, where good food is promoted with things such as the Food Network, competition television shows, as well as the news media, which are all helping people connect better with food. Before In the past, Americans ate for survival, but now they are alive to enjoy all that good food has to offer. A bakery has now become a place where you meet friends and
family and treat yourself. Consumers now read labels even more, and even large supermarkets such as Costco want quality food. Young professionals are the ones who keep the movement going especially those with kids because they want the best food for their children.
Michel Suas began baking at the age of 14. In his home country of France, he trained under several renowned chefs before moving to the United States in 1986. Suas is internationally recognized as an industry expert and is a strong advocate of using education to advance the appreciation and craft of artisan baking. The Bread Bakers' Guild of America awarded Suas the Golden Baguette in recognition of his contribution to the Guild and the artisan baking industry. The Bread Project named Suas an honorary life member in recognition of his guidance and support. “Advanced Bread and Pastry: A Professional Approach”, was written by Michel Suas and is a comprehensive guide to bread and pastry, designed as a resource for colleges and universities, private culinary schools, professionals, and dedicated enthusiasts. +++
The San Francisco Baking Institute (SFBI) was founded in 1996 by Michel Suas. SFBI is one of the leaders in artisan bread and pastry education. Their mission is to elevate the craft and appreciation of artisan baking. SFBI is the only school dedicated to artisan baking in the United States. SFBI is now even hosting a French Diploma IV Program, which is at a higher level than is required in France for a baker to open up their own bakery. In addition to educational programs, SFBI also consults with bakeries around the world. These services have helped many of the world's best-known bakeries develop operational efficiency and quality production. In San Francisco, CA, SFBI runs an artisan bakery called Thorough Bread and Pastry. +++ Website SFBI: www.sfbi.com
+ bbi: How does it affect artisan bakers?

+ Suas: Right now, the emphasis in bakeries is on better nutrition, flavor, and lower protein (gluten) flour in order to respond to people with gluten intolerance or discomfort. Also, the introduction of ancient grains and cereals to baking ingredients will become more widespread including signature grains that are milled at the bakery to make whole wheat bread with fresh flour. Local small retail bakeries are coming back to downtown, and large cities have a more modern approach including a coffee culture where people can treat themselves or have a treat with family and friends. We see this as a modern trend viewed as a bar during the day with sugar replacing alcohol.
+ bbi: How can bakers keep up with this trend? Do you have any tips for formulation and/or processing?
+ Suas: You should take note; Clean Label is not a trend but an evolution of what the baking movement started 30 years ago. The artisan baker began to, and still continues to improve by adding ancient grains and recently the larger bakeries began changing due to demand.
+ bbi: Do you have any tips for bakers wanting to reformulate or develop new products to meet this demand for Clean Labels?
+ Suas: A good baker should be able to reformulate any product, but it’s important not to over complicate the process. Find a good source for ingredients, especially flour, but don’t over price your food costs by using ingredients that are way too expensive. Long fermentation and adding preferment dough will replace any chemicals that potentially might have been used, resulting in great flavor and health benefits.
+ bbi: Can you tell us a little bit more about SFBI?

+ Suas: The SFBI (San Francisco Baking Institute) always works to promote and support better quality baking. We were able to offer products made with ancient grain about 15 years ago when these were expensive and hard to get, but now larger distribution systems are in place at a more affordable price.
+ bbi: What do you think the future trends will be?
+ Suas: Besides ancient grains, the big movement is towards whole wheat, and fresh milled bread Viennoiserie is the big winner when it comes to new trends. I hope that gives you an idea of what is happening in the US bread market, but you should also note that there are movements in South and Central America towards better quality and healthy bake products.
+ bbi: Mr. Suas, thank you for the interview. +++
According to the trade fair, the visitors included food retail purchasers, importers, wholesalers and representatives from the food service sector. Around 2,500 exhibitors from 40 countries provided them with information about their products.
+The 7th TUTTOFOOD B2B trade fair took place in Milan, Italy, from 6th to 9th May 2019. This food fair attracted chiefly Italian visitors. However, the trade fair company’s primary aim is to make the exhibition better known, mainly abroad. The fair is on the right road in this respect: 82,551 visitors from all over the world made the journey to the trade fair grounds in Milan. According to the organizer’s report, a total of 21% of the visitors were from abroad, most of them from the USA, Spain, France, Germany, England, China, Canada, the Benelux countries and Japan, as well as from Russia.

The halls are divided into various areas such as kosher, halal, wines, oils, fish, meat, cheese, pasta, frozen products and baked goods. However, exhibitors from the “bakery” area are distributed among various halls. This leads to a mix of various different food producers, so potentially interested buyers needed to work through the various halls, for example they had to look for dough piece suppliers in the frozen foods hall. On the other hand, cookie and panettone manufacturers, for example, were all together in the “Sweet” area. A great diversity of panettone manufacturers showed a wide variety of creations of this specialty Milan cake on their trade fair stands. In addition to classic baked goods made with candied fruits and raisins, panettone producers show these wheat baked products in a variety of sizes (from 100 g to 1 kg) and with various fillings, e.g. with zabaglione, pistachio or grappa crème.
Visitors were able to find frozen baked product manufacturers, e.g. Wolf ButterBack, in the other halls. Beldessert from Belgium, a private label producer of muffins, cheesecake and other desserts, was also represented. The Italian producer Unigel was noticed in the frozen area with schiocco, a combination of a croissant and a bread roll. This baked product is said to promise the enjoyment of a cake and the calories of a roll. A schiocco has





a crisp crust and a soft crumb. The schiocco has already been produced and marketed in Italy since 2011, and demand is growing. Unigel now wants to increase exports of this frozen baked product, which is why the bakery participated as an exhibitor at the TUTTOFOOD trade fair. The pastries are offered in various sizes (35, 65 or 100 g) and with different flavors, e.g. with olives, garlic or rosemary.
The Bäckerei Lemayr bakery from South Tyrol was represented. A group of experts is available here to develop individually customized solutions for major customers. The bakery exhibited various pizza snacks, small frozen baked products and breads.

In the fine pastries area, RICOCREM COZZO s.r.l. offered frozen goat’s cream cheese to fill cannoli. This ricotta is already prepacked (1 kg) in a disposable piping bag, but the filling is also available in packages holding between 1 kg and 21 kg in pistachio, chocolate and natural flavors, and with chocolate pieces.
Cupiello, a producer of frozen baked goods in Naples, focuses on “vegan” and “organic” trends. Its trade fair presentation centers on various croissants and cakes.

The trade fair is suitable for buyers and product developers in the baked goods sector, and due to its international orientation could also be a springboard for suppliers of dough pieces, for
















example. However, the majority of both visitors and exhibitors are from Italy. Visitors will gain an insight into the Italian food producers’ market. It was also slightly difficult for visitors to the trade fair to converse with exhibitors from Italy, since many of the catalogues were not translated, and none of the staff spoke sufficient English.
Baking sector exhibitors are also scattered across the entire trade fair grounds, which means long walking distances. This can mean that one is more likely to “stumble” on an interesting manufacturer at random. Altogether a B2B event with an international flair. The eighth TUTTOFOOD event will take place from 17th to 20th May 2021. +++
++ Unigel, a producer of frozen baked goods, wants to make its schiocco (Italian flaky bun) better known. The pastries are offered in various sizes (35, 65 or 100 g) and with different flavors, e.g. with olives, garlic or rosemary








Mecatherm has developed a new dough divider, the M-NS, presented for the first time at the 2018 iba trade fair.

+Mecatherm’s new Type M-NS dough divider model operates volumetrically. The plant is compact and can divide and mold even doughs with a high dough yield and long dough rest times and can deposit them, e.g. into pans or pan clusters. Dough pieces can weigh 100 to 900 g and the plant achieves an hourly output capacity of up to 2.5 tons of dough. According to the manufacturer, the divided dough pieces are not subject to any stress. Mecatherm says the combination of stress-free dough pieces and subsequent molding ensures that the end-product shows improved oven spring and develops a thin, non-dry crust together with a light, fluffy crumb, just as a French baguette should be.
The M-NS dough divider needs no molding machine, laminating roll or multi-roll. The division process starts once the dough is centered. After being divided, the individual dough pieces are separated and their weight checked. If the latter



does not agree with the target weight that was set, the dough piece is rejected. The density of the dough is also calculated. The manufacturer promises that the weight of the dough pieces always remains identical, irrespective of dough density. It also says the system responds automatically to dough density changes, e.g. in the event of a production interruption.
The machine is operated via a display, where the operator simply enters two values: target weight and deviation tolerance. The dough divider does everything else automatically, and even independently resets itself if deviations occur. Its good accessibility and easy cleanability are also beneficial. The new dough divider is EHEDG-certified (EHEDG: European Hygienic Engineering and Design Group), so it conforms to the hygiene criteria specified by the EHEDG. Moreover, it is said that the dough divider can also be integrated into existing production lines. +++

UrkornCakeMix combines modern baking technology with the age-old knowledge of traditional grains. Successful baking of timeless classics, like sheet and shaped cakes, or trendy American Cookies has never been easier. www.backaldrin.com

New digital technology provides a better way to measure humidity in proofers, oven, dryers and cooling tunnels.
+The new Reading SCORPION ® 2 Digital Humidity Sensor is designed to measure the absolute moisture content, of the thermal environment, in both heating and cooling processes. It is applicable to proofers, ovens, dryers and cooling tunnels. Mechanically the Digital Humidity Sensor is comprised of a Bulk Air (dry bulb) temperature sensor, two inputs for Product Core Temperature Measurement and a proprietary humidity sampling system to measure Dew Point Temperature, Absolute Humidity and Relative Humidity. The sampling system contains patent pending Anti-Saturation Technology™ allowing measurements in very high dew point environments such as steam injection. The Digital Humidity Sensor is engineered to be compatible with direct gas fired (DGF) ovens. Unlike oxygen sensor technology, which can be off by as much as 25% due to combustion gases in DGF ovens, the accuracy of the digital humidity sensor remains the same regardless of the oven platform. The Humidity Sensor travels through the process with the product, yielding a precise profile of moisture experienced by the product.
In high temperature applications above 100°C (212°F), absolute humidity is displayed. The user can choose between % Moisture by Volume or Humidity Mass Ratio (kg water/kg dry air or lb water/lb dry air). In low temperature applications below 100°C (212°F), % Relative Humidity is displayed. In both high and low temperature applications, the dew point temperature and dry bulb air temperature is displayed. Humidity in ovens is generally controlled by extraction
Humidity in a thermal process interacts with the product. The moisture in the environment often comes from the product itself and represents a delicate balance affecting finished product quality in many ways. For example:
+ The amount of moisture left in a product can determine its shelf life.
+ Reduced evaporation can keep the surface of a product moist, allowing it to stretch, preventing cracks.

+ Low humidity in a cracker oven can cause blisters leading to undesirable dark spots and excessive breakage.
+ The lack of humidity in a cookie oven can cause case hardening preventing internal moisture from escaping leading to checking (the spontaneous cracking of the cookie after baking).
+ High humidity in bread ovens produces the desirable glossy crust seen on many bread products. For this reason steam injection is often used.
+ High humidity will assist with the killing of pathogens, like salmonella, potentially found in surface toppings.
Product throughput kg/hr (lb/hr) can also be affected by when and how much moisture builds in a process. Moisture laden environments reduce baking efficiency, thereby reducing product throughput. +++
fans and dampers. Here the sensor is used to display the shape of the humidity profile as well as the peak moisture value obtained and where. In proofers it is used to document the temperature and relative humidity of the proof cycle.
In cooling tunnels it is used to monitor dew point temperature, preventing condensation on the product surface which causes blooming.
Technical Summary:
+ Number of sensor elements: 2
+ Product Probe Inputs: 2

+ Data available for display
- Dry bulb air temperature (°F or °C)
- Dew point temperature (°F or °C)
- % Moisture by volume
- Humidity mass ratio (lb water/lb dry air or kg water/kg dry air)

- % Relative humidity atmosphere
+ Sensor type: Capacitive humidity chip and type T thermocouples
+ Operating Temperature Range: 32°F (0°C) to 662°F (350°C)
+ Accuracy: ±5% of full scale for Humidity and Dew Point
+ Response Time: t60 = 3sec in air at 200 ft/min (1m/sec)
+ Dew Point range: 32°F (0°C) to 212°F (100°C)
+ Relative Humidity Range: 0 to 100% RH Atm
+ Absolute Humidity range: 0 to 100% Moisture by volume
+ Dwell Time: See Digital Humidity Sensor Dwell Time Graph
+ Battery running time: 4+ hrs. +++
Humidity Sensor: NEW Digital vs. OLD Analog
Plant engineering redesigned: We offer you the choice rather than ready-made kits – because we integrate processes, not just parts – for more efficiency, flexibility and security. Innovative plant designs from the plant architects. For a perfect dough all along the line.
Staff in the American supply chain centers of Domino’s Pizza produce dough for franchise outlets, among others. This also guarantees the quality of the pizzas.


+Das D omino’s Pizza, an American listed company, specializes in producing and supplying pizza. The company operates mainly in North America, Europe and Japan. Domino’s in the USA and Canada relies on supply chain
centers to produce pizza dough for the branches, among other things. There are 18 of these distribution centers in North America alone. They vary in size, the smallest serving around 125 branches and the biggest approx. 650 branches. There are also supply chain centers in Alaska, on Hawaii and five more in Canada. On the one hand, the task of these supply chain centers is to check raw materials quality, and on the other they guarantee that each pizza in every outlet has the same flavor.
One of these North American distribution centers is at Hartford, Connecticut, in the USA. It consists of a building with an area of approx. 3,715 m 2 that serves about 400 branches in New England, upstate New York, Buffalo, Rochester and New York City. The respective franchise branches in this arrangement have a supply plan that provides for one or three deliveries per week. Branches can submit their orders up to midday each day. These orders are collected and pooled. Production in the distribution centers is then planned, and transports are organized in such a way that they can be optimally used. This involves trucks starting deliveries on the same evening. A delivery to the Bronx, New York, for example, needs about a three-hour drive, but it can still be received before midnight on the same day if the branch orders by midday. Half of these deliveries take place overnight when no-one is in the branch. The drivers open the branches, deliver their goods,
and lock up afterwards. It’s the best and quickest way to deliver in big towns with a lot of traffic.
Staff in Hartford load goods into around 20 transporters every night. These leave the center from 20:00 hrs. onwards. Each truck supplies 10 to 12 branches, starting with the branches that are furthest away. The branch furthest from the distribution center in Connecticut is in Maine, which needs an eleven-hour journey. As well as delivering pizza dough, the distribution center acts as a redistribution point for all the items needed to operate a branch of Domino’s, including cheese, salad, paprika, desserts and even serviettes etc. For this, the distribution center carries up to 200 article items. This process guarantees that branches don’t need to worry about running out of a particular ingredient or article; they must just look after the order and receiving the incoming delivery.
The Connecticut supply chain center produces around 140,000 fresh pizza dough balls per day on six days a week. Each dough ball is made from six basic ingredients: water, flour, salt, oil and yeast, together with sugar. A special “Domino’s ingredient” – the so-called “secret ingredient” – is also added to turn the dough into Domino’s dough. The company was unwilling to give away anything more.


Dough production in Connecticut starts at 3:00 a.m. and continues until all the orders from the branches have been worked through. The center has two flour silos holding approx. 31 tons of flour per silo. Between 10 and 14 trucks deliver wheat flour to the center every week. Dough preparation starts with batches weighing approx. 230 kg. A total of three Diosna wendel mixers are in operation in Connecticut, so production can continue even if one mixer breaks down.
After all the ingredients have been put into the mixing bowl, the bowl is rolled into the Diosna mixer by hand. The ingredients are mixed and kneaded for about five minutes, after which a sample is taken from each batch to check its temperature and dough elasticity. After mixing, a bowl tipper is used to transfer the dough to an AMF dough divider. Knives cut the dough to the correct size and/or weight. This is followed by round-molding.
All the balls of dough then pass through a metal detector before being loaded into blue crates by hand. Each plastic box holds an average of seven dough balls, although this can vary depending on their size. The crates are then immediately taken into a cold store where the dough is cooled down from 26.7°C to 4.4°C. This must happen quickly so the dough does not already develop in the supply chain, but only when it is in the branch. The specification is that the dough must be brought from the mixing bowl into the cooler within 15 minutes. Staff stack the crates crisscross in the cold store to ensure efficient removal of heat and moisture from the dough balls. After cooling, the boxes are then stacked one on top of another
before being transported to the branches. The dough must now always be stored at a temperature between 0.5°C and 3.3°C. In this respect, maintenance of the cooling chain is what decides the dough’s quality.

Domino’s has numerous recipes for its own branches. However, it also produces dough balls for school meals programs in the USA. In this case, the recipe must conform to government school meals specifications. However, these rules applicable to pizza can vary from one school district to another. Pizzas supplied to cater for children in schools are then baked in Domino’s branches.


We have a closure for every production need and labels that drive sales.

Labels get you noticed

• Eye-catching on the shelf
• Drives incremental display
• Instant brand recognition
• Wide variety of label options to meet your needs






Labels drive sales


• Increase sales up to 15%
• Use a promotional hook to gain shelf space



• Connect o ers to your other products for co-purchase




• Use Kwik Lok labels to amplify your marketing message




• Link digital content and social media via Quick Response (QR) codes




• Use labels for Immediate Redemption (IRC) and bounce-back coupons






• Cross promote with other products

• Create brand and occasion o ers that drive loyalty and transactions

All the dough used in branches of Domino’s is fresh, and is never frozen. However, the fresh dough is not yet ready for use when it is delivered, and must be chilled for one or two days before being used in the branches. The dough should then be processed in less than one week.
There are around 175,000 blue crates in the Hartford, Connecticut, center to transport dough balls. After a delivery has taken place, the driver takes the empty crates from the branch back to be cleaned and refilled in the distribution center. The distribution center has a crate washing plant. The boxes are washed, disinfected and stored until they are refilled with fresh dough. The entire washing process takes approx. 20 minutes.
After being loaded with dough, the edge of the box is labelled using washable food-safe ink, stating the production date and time of day, together with the size and type of dough. This allows employees to determine the dough’s proofing time and shelf life. The fresher the dough, the longer it must proof in the branch before being used. The longer the transport time to the branch, the sooner the dough becomes ready for use.

The crates are not all the same color. A few of the boxes are dark blue, meaning that one crate must remain empty and must be put at the bottom of a stack. There are even a couple of red crates, although these come from distribution centers in North Carolina or Georgia. If the plastic boxes are damaged, show cracks or are discolored, they are recycled.
Domino’s operates worldwide and employs more than 14,000 staff who generate an annual turnover of around USD 2.4 billion. Around 150 staff work in the Connecticut supply chain center.
Domino’s was founded in December of 1960 by Tom Monaghan and his brother James. They got their start in Ypsilanti, Michigan originally purchasing a pizza store being called “DomiNicks”. One year later, James traded his half of the business for a Volkswagen Beetle. You can still see the VW Beetle that Tom used to buy his brother out from the business at their current headquarters in Ann Arbor, MI.
Domino’s began franchising with three flagship stores. The first franchised store outside of Michigan was in 1967 located in Burlington, Vermont, and is still there to this day. The Domino’s logo has three dots on a domino piece, each do representing one of these original stores. Originally, they planned to put one dot per store on the logo, but now with over 15,000 stores worldwide, that logo would look like one large dot.
Larry Manning, Supply Chain Customer Service Director, says “It’s a company in which you can grow old.” Manning began his career as a customer service employee in this distribution center about 30 years ago. According to Manning: “Everyone knows their job; the job is to sell more pizza and to have more fun.” That makes the manager proud of the centralized production of pizza dough. +++
To allow the franchise stores to focus on making pizza, Domino’s began controlling the supply chain process in 1972. The goal was to create a one-stop shop for all the operating needs of all franchises. This strategy would allow each store to make one phone call to order all its ingredients, which would save the stores a lot of time and money. This strategy would also help ensure quality and consistency of ingredients, as well as create one brand for one global organization whose clear goal was to sell pizzas all around the world. Domino’s stores are now located in over 85 countries worldwide.
Domino’s Supply Chain Centers keep tight control over the quality and pricing of ingredients to offer a competitive advantage. All ingredients are controlled to ensure every pizza in every store has the same taste. After 47 years, there are now 18 distribution facilities in North America alone. These vary in size with the smallest servicing approximately 125 stores and the largest serving about 650 stores. Additionally, there is one in Alaska, one in Hawaii as well as five more in Canada.








Bundy Baking Solutions announced the launch of a new business, Synova LLC, to manufacture and distribute baking release agents. The new business, located in Westerville, Ohio/USA, will offer release agents for baked goods including bread and cakes, as well as food-grade release agents for troughs and other bakery equipment. The 70,000 square foot facility has been fitted with new, state-of-the-art equipment with automated manufacturing systems to meet the highest sanitation, reliability, quality and sustainability standards. Synova will employ up to 20 people including a team of experienced R&D scientists for product formulation and new product development. “We are very excited to add high-quality release agents to our product offering,” said Gilbert Bundy, Bundy Baking Solutions CEO. “The new release agents combined with our pans, pan coatings, pan refurbishment services and experienced sales force gives us the ability to provide comprehensive service to our customers to ensure they get the longest, most productive life out of their baking pans.” +++

FRITSCH GmbH has filed an application for the opening of insolvency proceedings for itself and the companies FRITSCH Holding AG, FRITSCH Vertriebsgesellschaft GmbH, FRITSCH Bakery Systems GmbH, all from Markt Einersheim, and FRITSCH Service GmbH from Heilbad Heiligenstadt – with the district court in Würzburg in charge due to imminent insolvency.


The Local Court will now appoint a provisional insolvency administrator who will, together with the Management Board examine restructuring options and the restructuring measures already initiated, with the aim of continuing the business operations of the companies.
The group of companies wants to preserve the best possible opportunity to sustainably restructure itself through insolvency proceedings. Alexander Schmitz, who has been CEO of FRITSCH Holding AG for three months, sees a good chance that this can be successful: "FRITSCH has a very good reputation in the market, the products are of high quality and in demand, despite intensified competition and structural changes in the baking industry," says Schmitz. +++
After a construction period of 20 months and an investment of about CHF 50 million, Bühler Group has officially opened its CUBIC innovation campus with eight Application Centers. “We are with this driving forward our strategy of innovation, training, and development,” says Stefan Scheiber, CEO of Bühler Group. The new innovation campus is integrated into the Bühler site in Uzwil as the bridge that links the development, engineering, and design teams with the modernized Application Centers and the factory. This enables Bühler to develop solutions together with customers, start-ups, and industry and research partners up to the point of market maturity with much higher speed and efficiency. “The CUBIC campus will become the epicenter of our collaborative ecosystem,” says CTO Ian Roberts. +++
In its centennial year, MIWE Michael Wenz GmbH has expanded its international presence at a strategically important location in the Middle East and Africa by opening a new subsidiary in Dubai, United Arab Emirates. The ninth subsidiary of the German bakery systems manufacturer based in the Dubai Silicon Oasis free trade zone started operations. It will serve the United Arab Emirates (UAE) alongside other countries in the Gulf Cooperation Council (GCC), including Saudi Arabia, Kuwait, Oman, Qatar and Bahrain, as well as sub-Saharan Africa and Pakistan.

Pizza is one of the most popular foods worldwide, and various plant constructors offer industrial pizza lines. Here is a small overview of the manufacturers and methods.


P izza can be produced to a customer’s specification to comply with almost all personal preferences and dietary or religious restrictions. A pizza can also be adapted to a series of regional preferences. In addition there are variations of pizzas and pizza-like snacks. Industrial pizza line manufacturers offer a very wide variety of solutions and processes. Here is a small, albeit incomplete, overview of plant constructors and processes.
According to the manufacturer, FRITSCH pizza lines start with a dough sheeting line operating according to the
FRITSCH SoftProcessing © method to carefully shape the dough into a dough sheet while retaining the structure of soft doughs. For this, the SoftProcessing © method uses a satellite head. The satellite head has eight rollers with a non-stick coating, and moves in the same direction as the dough sheet. Each of the eight rollers moves in the opposite direction to the dough sheet. After the dough has been reduced to the required dough sheet thickness, and depending on the process, the dough can go into the proofer, for example. To create a slightly irregular shape, a poking roller can be used to poke the dough after proofing, thus simulating manual make-up. A FRITSCH IMPRESSA pizza line can be used to produce Italian pizza, American pizza, calzones and flatbreads.
Generally speaking, there are two ways to produce pizza crusts, either from a doughball or by cutting out on a dough sheeting line.
FRITSCH specializes in dough make-up, while FRITSCH Bakery Systems also offers to plan entire pizza lines extending beyond the dough sheeter line. FRITSCH Bakery Systems acts as a single provider to plan the design concept and coordinate the suppliers of the ovens, freezers and packing plants to offer a turnkey solution for the whole pizza line.
The Kaak Group can also offer turnkey solutions to fabricate an industrial pizza line. Combining together various business divisions (DrieM, Daub, MCS, Benier and Kaak FPS) enables pooled expertise within the company to be utilized to create a design concept for a pizza line that can handle the variations

VMI offers state-of-the-art mixing technologies to meet the varied requirements of the baking industry






VMI is THE mixing company.
in pizza manufacture. These turnkey lines offer capacities of up to 6,000 pieces/hour for standard pizza (or 4,000 pieces/ hour for gluten-free products).



A Kaak integrated pizza production line offers all the various components needed to make pizza, including: metering, mixing, molding, proofing, baking, cooling, topping and freezing.
Mixing and make-up are provided by Benier, ovens by MCS, for example, spiral coolers by Kaak and conveyor belts by Multiparts. MCS also offers MDD mixing systems. There is also a pizza press from Italy. After the dough has been molded into balls, it is placed either on trays or onto a belt and sent to the MCS hot press. Dough balls deposited onto trays are first of all gently pressed onto the trays without any heat. The dough pieces are then put under a presser head that applies pressure and heat to press the dough up to the tray walls to create a rim on the crust. Without a tray, the dough can be pressed on a conveyor belt. Dough pieces arriving from the proofer are lined up in rows to be carried under the presser heads. Kaak goes on to say that this allows the traditional dough handling method. MCS also makes some proofer variants for these hot-pressed crusts. As well as plants to produce pizza crusts from dough balls, DrieM also makes a dough sheeter with which pizza bases are cut out by die-cutting.
The biggest pizza line fabricated by AMF Tromp was installed in the USA and produced 100,000 pizza crusts per hour. The Group supplies customized lines with which the customer can choose whether his pizza crust is to be produced either from a dough ball or from a dough sheet. For this, as the company explained, the Tromp dough sheeter line offers gentle dough handling that retains the dough’s structure, consistency and volume.
AMF Tromp uses a dough divider for crusts made from a dough ball. This offers high weight accuracy and a greater capacity than a dough sheeter plant.
Various topping and decorating systems are offered to apply ingredients such as cheese, meat and vegetables. Excess ingredients are recycled to the ingredients cone. AMF Tromp proofer systems are also tailor-made. The oven designs can be equally customer-specific. Thus AMF Tromp offers an integrated pizza solution through partnerships with AMF, AMF Den Boer and Reading Bakery Systems.
Rademaker offers a pizza line capable of producing pizzas in various shapes and sizes, as well as alternative products or variants such as pizza baguettes and pizza sticks. The Rademaker pizza line can process between 500 kg and 6,500 kg/hour of dough. In this respect the company specializes in dough sheeter technology. With a working width of 600 to 1,600 mm, the dough sheeter line provides the flexibility needed to manufacture a wide range of products and shapes. Capacities depend on the product and dough thickness. Proofer cabinets can be set up “in line” if necessary, to proof dough sheets before cutting out the product. Rademaker’s pizza topping solution is also said to be a modular system that guarantees the flexibility and quick changeover needed to produce a pizza topped with tomato sauce, vegetables, cheese, meat and other toppings. This allows the plant constructor to offer customized solutions for pizza production. +++


Some manufacturers believe a pizza doesn’t always need a wheat dough crust. Nowadays, for example, there are alternatives made from cauliflower, vegetables or even chicken meat.


+Traditional pizzas usually contain a crust made from six basic ingredients including: flour, sugar, water, salt, oil and yeast. The crust is the base used to deliver flavor through the sauce and toppings. Recently manufacturers have begun to differentiate themselves with unique offerings in the crust, such as various vegetable alternatives, seeds, flours, which offer different flavors and nutritional profiles.
According to Mintel’s latest U.S. pizza market report, three quarters of pizza consumers are willing to spend more on better quality frozen pizza. A new-comer in the US pizza market is Caulipower ® which started its first year with $2.1 million US sales. Caulipower® is a gluten free pizza crust that is made from cauliflower, brown rice flour, corn starch and tapioca as the base of the crust instead of wheat flour. The paleo version of the cauliflower crust is grain free with the main ingredients including cauliflower, almond flour, cassava flour, and tapioca flour.

In addition to ready-to-bake frozen cauliflower based pizzas, Cali’flour Foods offers frozen plain cauliflower pizza crusts and flatbreads that are ready to be topped with fresh ingredients at home. These crusts and flatbreads mix cauliflower with mozzarella cheese and egg whites to provide gluten, grain, and nut free pizza crust, ready to be topped. These crusts are a good source of protein and were formulated with the paleo and ketogenic diet in mind with 1 g of net carbs per serving. The flat breads are only 50 calories with 5 grams of protein and 3 grams of net carbs. Cali’flour Foods also offers a plantbased pizza crust that is vegan. This crust is made from cauliflower, sesame seed flour, sunflower seed flour, olive oil, psyillum husk and nutritional yeast. The vegan crusts are offered in three flavors: plain, spicy jalapeño, and Italian.
Realgood Pizza Co offers a unique pizza using chicken and cheese as the crust base for a high protein and low carb pizza that is gluten and grain free. In addition to the chicken crust pizza, Realgood also offers a cauliflower crust made from the base ingredients cauliflower, cheese, and egg. These crusts are providing more options for gluten-free diets.
Outside of the United States, Dr. Oetker’s “Yes It’s Pizza” is selling vegetable-based crusts with at least 38% vegetables in the crust and as a topping. These thin crispy crusts include varieties with beetroot, spinach, and cauliflower. The crust of the pizza is even the color of the vegetable, so the beetroot crust is pink and the spinach crust is green. While these pizza crusts still contain wheat flour, for the consumer looking to increase vegetable intake and try new flavors, this product is an interesting option.
Manufacturers are also offering consumer ways to increase creativity at home. Nestlé Wagner is offering ERNST WAGNER’s with three new types of fresh dough ready to be decorated and baked at home. The varieties of fresh dough include “Pizza” in a rectangular shape to fit in the baking pan, “Flammkuchen” being extra thin and crispy also the shape of a baking pan, “Pizza & Focaccia” for round and fluffier pizza.
Other things that are showing up are dough formulations, especially gluten-free products, which include ancient grains such as quinoa, sorghum, amaranth, teff, and buckwheat to provide variety in flavor and textures as well as health benefits while maintaining a clean label.
These new and interesting pizza crusts are pushing the boundaries on what can be used as a pizza crust. The thing these crusts have in common is targeting the trend towards healthier pizza, cleaner labels, and alternatives for all food products. +++


The Berlin-based Freiberger Group is one of the pizza market’s most important players. A 100% subsidiary of Südzucker AG, it produces frozen and chilled pizzas, frozen pasta dishes and snacks, and is clearly focused on the own-brand retail business. Freiberger says it makes around 700 million frozen and chilled pizzas per year. The Berliner Morgenpost (newspaper) reports that the group is one of the world’s biggest suppliers, with a 2018 turnover figure of almost EUR 1 billion. The company itself does not give any turnover information. According to Freiberger, the number of employees is around 3,500, of which just over 600 work at the Berlin head office.
In total, the Group has eleven locations in Europe and the USA. Products are marketed in 30 European countries and in the USA, Canada and South Africa. The Freiberger company’s web site says it is the market leader in frozen and chilled own-brand pizzas in eight countries that between them account for 80% of worldwide pizza sales.
The Group took over the Magdeburg-based frozen pizza producer HASA in May 2017, and the US competitor Richelieu Foods in late 2017 as well, for which according to the Berliner Morgenpost it paid around EUR 350 million.








As a result, Freiberger now owns five factories in the east of the country. Its customers include almost all the USA’s major retail chains. According to the report, the management has big objectives for the new US subsidiary. Although the US market was previously also served from Europe, the number of dough pieces that found their way onto the other continent is said to have been clear.

Head of Sales Thomas Schulz told the newspaper that together with Richelieu, Freiberger will now grow in the USA. Americans in the US now spend around USD 4.5 billion annually on frozen pizzas, but up to now they have relied mainly on brands such as Dr. Oetker, Schwan’s and Wagner. Supermarket chains could use Freiberger’s own brands to offer favorable alternatives. That’s also why the company sees great potential in the US market. According to HansDetlev Schulz: “We have a 20% share in Europe, and should be able to achieve more in the USA.” +++











Thanks to special C-Proof perforated stainless steel swing-trays, the new industrial CleanProofer proofer is said to be gentle on dough, low-maintenance and hygienic in operation.

Werner & Pfleiderer Haton BV presented the CleanProofer at the 2018 iba trade fair: this industrial proofer is now in use at a bakery in the Netherlands. The company reports that its special C-Proof perforated stainless steel swing-trays make the plant especially dough-friendly. The CleanProofer also avoids traditional turning stations, instead of which it has a continuous system offering the benefit of a “buffer function”. The special C-Proof swing-trays use a 90° turn to deposit dough pieces onto the outgoing conveyor belt, which the company also says is synchronized to the speed of the CleanProof chain, thus moving the dough very gently.
The CleanProofer, positioned in an insulated housing with a separate air-conditioner installation, is suitable for processing soft, sticky doughs with a rather high water content.
The company also says the number of moving parts in the CleanProofer is minimal, leading to minimum maintenance and cleaning costs. The perforated stainless steel swing-trays can also be cleaned using a high-pressure water jet.
Proofing time is up to 90 minutes for 1,000 grams, and the capacity is up to 10,000 pieces/hour.

The capacity of the first CleanProofer installed at a bakery in the Netherlands is 3,500 pieces/hour, with an intermediate proofing time of 45 minutes. The machine is also ready for Industry 4.0: a wireless sensor transmits all the production data, e.g. temperature, pressure, slope and air humidity, live to a control panel, tablet or smartphone. The company says the 3-D-Twin controller also allows maximum control from anywhere. +++




























Want superior hydration without adding excess heat to your dough? New Hydrobond technology delivers. Not only does it blend dry and wet ingredients with unmatched efficiency, it also:
• Requires no additional floor space





• Reduces your total mixing time
• Cleans quickly and easily







• Reduces heat attributed to mixing energy


• Allows you to mix more dough with same size continuous mixer






 Booth 5521
Booth 5521
 BY READING BAKERY SYSTEMS
BY READING BAKERY SYSTEMS



“Separating agents are designed to keep adjacent materials separable.” It sounds so simple when Wikipedia is asked to define the term. On closer inspection, it turns out to be a complex business area.
+A global player based in Bad Salzuflen has now specialized in this field – DÜBÖR Groneweg GmbH & Co. KG. Describing itself, the company says it supplies “to suit your mold”, i.e. it makes both the separating agents and machines to match. It has two production sites: Bad Salzuflen (Germany) and Ottmarsheim (France). Marketing takes place via seven sales departments of its own and 65 dealers worldwide. Sales manager Richard Jülicher stresses that “DÜBÖR is a growing company. We have become bigger little by little, i.e. in a healthy way.” It all began in 1961 – as a one-man business.

Horst Groneweg brought the company into being and established a business that also produced baking agents alongside separating agents in the early days. The company’s founder says “I used a conching machine to make enrobing chocolate; the product range also included crème powder and baking powder, but in the late nineteen-seventies I focused entirely on release agents.” Automated bread manufacture was emerging at that time, and Horst Groneweg accompanied it by automating the separation process.

DÜBÖR began by using emulsions as separation agents, and with an optimized recipe they are still in the product range today. For example, they are appropriate for large-volume bread production and to manufacture cake bases. Products in the second group, oil-wax mixtures, contain no water and are suitable as universal separation agents for bread and baked goods. Product group Number 3 comprises liquid separation waxes for high-performance applications, e.g. in steel belt ovens and to oil flat trays. Cutting oils for all types of bread slicing machines and dough dividers, and an organic range, complete the separation agent portfolio. They are joined by Group 5: spraycans, virtually the company’s “smallest machines”, filled with baking separation agent or cutting and lubrication oils. The company markets all its separation agents worldwide under the Trennaktiv brand.
By definition, baking separation agents are substances that facilitate the release of baked products from molds and trays, and keep baked goods separate when they are pushed together. They are processing aids, i.e. need not be declared on the label. They are safe for food contact nonetheless, and DÜBÖR complies with the IFS Food Standard. The products are kosher, halal and plant-based. The range of organic products carries the Bio-Green Seal certificate, and if palm oil is used, it is RSPO-certified. According to Groneweg: “Palm oil is an oil that has very good separating properties, and withstands thermal stress as well as the best, but it is being criticized. That’s why, for sustainability reasons, we are developing palm-oil-free alternatives for our customers.”
Soya and soya lecithin were already banned from products approx. 15 years ago.
Raw materials
Separation agents consist of non-hydrogenated vegetable oils, vegetable oil fractions, vegetable wax, lecithin, a natural antioxidant, a natural emulsifier and water (in the case of emulsions). They differ in their:
+ appearance, color and odor
+ viscosity and density
+ oxidation stability: a measure of their resistance to becoming rancid; the greater the oxidation stability, the more suitable they are for long-life baked products and confectionery (a minimum shelf life of up to 36 months is achievable)
+ smoke point: a measure of heat resistance
+ saponification number: a measure of combined and free fatty acids; it indicates the freshness of the oil, and should be less than 1
+ acid number: characterization of acidic components
+ iodine number*: a measure of the content of unsaturated compounds; the iodine number indicates the amount of iodine in grams that can theoretically be added to 100 g of fat. The more unsaturated bonds there are, the more iodine can theoretically be added, and thus the bigger the iodine number.
On the other hand, “resin-free” is not a criterion. Richard Jülicher explains that “Resinification just means drying up.” He says any oil will be “resin-free” as long as it is in the container, i.e. does not come into contact with air and light. Resin-free is purely an advertising statement. He says that in relation to oil, the description is wrong in any case. “Oil does not form resin when it dries up.”
DÜBÖR uses its own tanker trucks to collect the most important raw materials from the manufacturers. Organic oils are a particularly scarce commodity, and in fact they originate mainly from Austria. That’s why, as Horst Groneweg says: “We hold reserve stocks of our raw materials for months in advance, and for safety reasons we procure them from various different oil mills.”

Security is a keyword in another respect as well, and is one reason why the production operation doesn’t rest solely on one basis. According to Groneweg: “Although the main purpose of the Ottmarsheim works in France is to supply southern European countries, it would be able to take over the entire Bad Salzuflen production in an emergency, and
Founded: 1961
Managing Directors: Horst Groneweg (owner), Holger Groneweg
Employees in Germany: 86
Employees worldwide: 130
Production sites: Bad Salzuflen/Germany (separation agents and plant construction); Ottmarsheim/France (separation agents)

Sales Departments: 7
Distributors worldwide: 65
Sales region: Europa, Asia, South and North America, Australia
Export ratio: 40%
Sectors supplied: the baking and confectionery industry, meat industry; the pharmaceutical sector
vice versa. That allows us to give our customers such a high level of supply reliability.”


The separation agent also affects the result of baking. Groneweg says “It can produce a fine or coarse pore structure, and even influences the color of the baked goods. If an emulsion is used for a cake base, the surface will show rather large vacuoles, whereas an oil-wax mixture will create a smooth, fine surface. Producers of long-life baked goods need rather high-quality oils with a long shelf life. After all an ice cream cone, for example, should have a 30-month shelf life. The separation agent must be able to equal that. Steel belt ovens need the highest possible quality of fat.” The challenge in this case is the enormously high release of heat.

DÜBÖR uses its own supply fleet, including eleven truck trailers, to deliver separation agents within Central Europe. Groneweg says: “Our trucks are the packaging. The fact that we drive them to customers ourselves is part of our service. We not only supply, we also take back empty containers at the same time. No haulage company in the world can offer that. We don’t achieve it as far as Japan, of course, but we are on the road in the neighboring territories, i.e. as far as the Netherlands, Denmark, Austria, Sweden etc.”
As Richard Jülicher explains, “We build ‘custom-made’ spray plants. When considering which is the best plant for a customer, of course we take into account data such as the product to be separated, the baking pan, belt speed, physical dimensions, the spray pattern, the separation agent being used, and many other individual customer requirements.”
Separation agent spray plants in the TSA series are built in all the various sizes and for all imaginable hourly capacities. Entirely individual, to match the customer’s need. The TSA 800 are fabricated with their own transport system, or as an attachment or bolt-on device for the customer’s existing conveyor plant and lines.
On the subject of spray nozzles, DÜBÖR showed its latest generation of nozzles at the iba 2018 trade fair – with a hygienic design, free from dead spaces and with smooth surfaces, which enables the spray nozzle heads to be cleaned more easily. And something else was on the serving tray in Munich: the PSU – the Precision Spray Unit – that sprays the minimum amounts of separation agent, works more precisely and faster, and provides a noticeable hygiene advantage because less separation agent is sprayed. (on this topic, see also our article in Issue 1/2019, Page 30.)


Knowledge is power. When detailed know-how about sheeting processes, production line operation and dough processing is lacking, problems affecting overall production costs and product quality might occur. In the Rademaker Academy, bakery knowledge is preserved and shared through education and training, enabling you to maximize the profitability of your bakery.

Greater process reliability, reduced resource consumption – when it comes to packaging fresh products such as baguettes or croissants, GEA`s latest generation of thermoforming packaging technology offers advantages.




+"Before developing the machine further, we undertook a customer survey", explains Volker Sassmannshausen, Product Manager Thermoforming. "Based on their feedback, we chose to focus on film unwinding and feeding, hygiene and overall handling. Consequently, the sealing station and bottom film infeed of the PowerPak PLUS thermoformer were completely redesigned to facilitate process transparency and traceability.“
The unwinding systems for both the top and bottom films have been optimized and are now motor-driven and synchronized with the machine’s advancing cycle. In combination with the innovative web tension system, they facilitate a controlled unwinding and a simplified and secure film path. Controlled unwinding in the bottom film infeed module
innovations in film unwinding and film run, the sealing station design has also been updated. The entire top film unwinding system is located in the area of the sealing station and easily accessed. Typical tolerances of the film reels like mis-alignment or curvature can be automatically adjusted. In addition, the sealing station structure has also been fundamentally improved and is now protected by vertically adjustable and transparent safety doors, which can be lowered quickly and easily when required, eliminating the need for loose, protective hoods.
Other significant innovations in the sealing station include the motor-driven evacuation and gasification valves in combination with pressure sensors. They enable individual, reproducible as well as product- and packaging-dependent processes. And, for example, under-, upper- and product vacuum are able to be controlled and monitored, ensuring the necessary process transparency.
The new thermoforming packaging machine has been in use at Handl Tyrol GmbH since the summer of 2018 for packaging bacon products. Working primarily with printed films, packing weights and sizes are constantly changing at Handl Tyrol. As a result of the technical innovations, the company see economic benefits as a result of shorter set-up times, which are now70 percent quicker and has also halved its film changeover times, with 75 percent less film being lost during changeovers and virtually zero packaging errors. +++
The Delhaize supermarket chain is one of the big food retail players. When the company renovated a supermarket in Melsbroek, Belgium, the investments included a new baking station in which the staff prepare snacks and baked products.


+The Delhaize company describes itself as a leading food retailer with approx. 6,637 shops worldwide, and around 369,000 employees. Its sales outlets serve around 50 million customers each week. Among other countries, the retailer is active in the USA, Europe (Belgium, Greece, the Czech Republic, Romania, Serbia & Luxemburg) and Indonesia, where the company operates various formats such as supermarkets, convenience stores, hypermarkets, specialist shops or filling stations. However, online retail is an important and growing sector for Delhaize. Nonetheless, the company also constantly invests in classical sales outlets, e.g. to distinguish itself from discounters and other competitors.
For example, the group has renovated the Delhaize supermarket in Melsbroek, very close to Brussels airport. The shop’s management also decided to renovate and redesign the baking station area. For example, new ovens were bought
to enlarge the selection of baked goods for customers, as well as to offer freshly-topped bread rolls and snacks. The supermarket and its baking station are open six days a week. Customers can shop from 08:00 until 20:00.
A total of six instore ovens is available to the personnel. Staff use two DILA Dual 10/5 and one DILA 10/5, e.g. to bake-off dough pieces. The Dual ovens offer a special feature in this respect: these instore ovens have a glass panel at the back, allowing customers to see through the oven’s baking compartment and into the bakery area. The equipment of these instore ovens also offers various options such as the e.CLEAN.SYSTEM ® , radial fans or high-power steaming. Networking the ovens via FilialNet, together with loading systems and TOUCH control, are also available as options. Delhaize currently operates this new type of demonstration
baking in around 20 supermarkets in Belgium. The company also arranged for employees to receive appropriate training from the German oven builder DEBAG. In addition to simply operating the ovens, of course, those responsible also considered it important that the results of baking should be correct.

The concept is well received by customers, and helps the retailer to achieve its aims of good baked product quality and a good price, combined with good service.
The management of the Melsbroek supermarket is pleased with the sales revenues generated by the bakeshop. For example, the company sells up to 400 freshly-topped bread rolls and baguettes each day (e.g. American basil for EUR 2.79). In addition, the market accepts individual orders from the nearby offices, and this service is also well received. Altogether, the market offers up to 50 different kinds of bread and around 60 bread rolls (e.g. a 55-g Kaiser roll for EUR 0.39). The selection also includes snacks and sweet pastries. The most



popular product is tinned tiger bread, which is offered in the weight range from 400 g (EUR 1.99) to 800 g. The proportion of organic baked products is around 20% (e.g. a 400-g organic bread with olives for EUR 2.45). There is also a special shelf for gluten-free baked goods, and chiller shelves for cakes, gateaux and sweet slices or baked products with crème. The majority of the baked goods (par-baked or even green dough pieces) are provided by the supplier La Lorraine.
The focus on demonstration baking combined with highquality baked products and fresh preparation leads to numerous baking operations. The DEBAG ovens have given no problems so far. As explained by International Sales & Marketing Manager Georg Schulze: “Up to now, only the oven door seals needed replacing. These are highly stressed due to the large number of baking processes, which makes changing them a part of annual maintenance.” Thus shopping at Delhaize can continue to be an experience for customers. +++








Hygiene sluices should be integrated into the operating procedure in such a way that the production operation is protected from possible contamination. Compact, tamper-proof installations are designed to guarantee this.
One of the obligations of baked product manufacturers is to determine the safety-critical work stages, to monitor them constantly, to document them and to implement appropriate safety measures. This also includes protecting the production area and/or bakery from possible contamination. That’s why many companies rely on a hygiene concept and on integrated hygiene sluices. Kohlhoff Hygienetechnik GmbH & Co. KG is one of the hygiene technology suppliers. Based on Unna, Westphalia, the company has developed, produced and marketed personal and industrial hygiene equipment, machines and plant for nearly 30 years. The company also offers hygiene-related advisory and planning services.

They offer a range focusing on products for cleaning, disinfecting and drying hands, boots and shoe soles. As the company says, these functions can be integrated into compact, tamper-proof hygiene sluices, thus protecting hygiene-sensitive areas of the business from possible contamination by employees. Kohlhoff has developed an individually custom-configurable CHECK-IN-STATION-HD for baked products manufacturers. It combines three hand cleaning, drying and disinfection components with a turnstile and shoe-sole cleaning module.
The washing area includes non-contact soap dispensing from a two-hand soap dispenser, said to be tamper-proof, after sensors built into the head element have detected both hands. Only after that can the flow of water be started by another sensor in the back wall. In the next step, a high-speed dryer (fitted with a residual water drain) automatically dries the hands in approx. ten seconds. Its factory-set air flow is activated after the sensor has recognized both hands
together. The turnstile releases the exit only when two-handed disinfection has also taken place. In parallel with this, two rotating brushes clean the shoe soles, usually dry, in the feed-through cleaning machine. Wet cleaning and disinfection are also possible. Optionally, the plant can also be equipped with a crumb tray that is easy to open, empty and clean. Hairnet and beard protection dispensers are available as extra components. Moreover, a paper hand-towel dispenser with a wastepaper basket can replace the electric hand dryer.
In addition, the number of components required and their arrangement in the room can be individually planned for businesses in which a large number of personnel need to pass through the installation simultaneously.
Customers can also obtain many Kohlhoff hygiene technology products from the suppliers MOHN, SAILER and ZINGEL. According to the company, these three firms are Kohlhoff marketing partners and/or agents.
ITEC, a Frontmatec Group brand, is another player in the hygiene solutions area. The ITEC brand portfolio extends from modular cleaning and disinfection systems and monitoring systems to comprehensive hygiene sluices. In the food hygiene area, the range starts with knife and apron cleaning plants and goes on to chemical-free surface cleaning by a UV-C tunnel. The ITEC hygiene technology brand’s exclusive marketing and service partner is in turn the PHT company.
The combined hand and sole cleaning stations in the ITEC Star Clean series are an example of an innovation in the

hygiene sluices area. For the first time, according to the press release, these now also include cleaning the sides of shoes up to a height of approx. 4.5 cm in their cleaning process. According to the release, the station can be individually configured and offers a fast processing procedure with a throughput capacity
of up to 20 persons/minute. The company also says that older systems can be retrofitted. The system has two brushes to tackle dirt on each side (above and below). The opposing rotation of the two lower sole brushes is designed as an additional guarantee of thorough cleaning. The sole brushes also drive the spiral side brushes that brush dirt downwards into the sump area. There is also a twin-track footstep guide. The brushes are removable to clean the machine.

The construction of the hygiene station is modular, and components can be combined together, so one component can consist of the sole and sole-side cleaning. Other modules ensure that every employee who passes through the hygiene station also has clean, disinfected hands. The station also takes care of security, as it does not release the motor-driven turnstile until cleaning is complete. Only then can the employee gain access to the production area.
The modular hygiene station is available as both a platform and a shaft installation variant for floor-level installation. The platform design in the dry cleaning variant is fitted with a drawer to collect dirt. The report goes on to say that this variant is particularly interesting for the baked goods industry. +++

Hands are the main transmission route (around 80 %) for pathogens and bacteria. The importance of the subject of hand hygiene becomes clear when that is borne in mind.
+Regular hand-washing can interrupt the infection chain, i.e. the transfer of microorganisms from hands to product, to machines and onto plant. Proper hand hygiene, especially after using the toilet, also includes disinfecting the hands after cleaning them. Regularly washing and disinfecting the hands is also indispensable when handling sensitive and/or easily perishable foods, e.g. in snack manufacture or in the confectionery area.
Thus compliance with hand hygiene is an important precaution in the framework of basic hygiene. It protects not only customers but also the employees themselves from infectious illnesses.
The majority of disease pathogen transfer is via hands. Hand hygiene is therefore of the greatest importance. This is illustrated by the swab test in Figure 1.

Numerous types of microorganisms that can cause infection or form disease-causing substances occur in foods. Here are a few examples from the baked goods area (including snacks/ confectionery/café):
Salmonellae: Bacteria that occur in uncooked eggs, poultry or meat. They cause diarrhea and vomiting.

Staphylococci: Bacteria that occur in the nose-throat region,
Cleaning and disinfection: when? Regularly before, after and between various work processes in the factory
How? By means of the resources provided, using a sufficient amount of cleansing agent, complete wetting, thoroughly spreading, and dry hand surfaces before disinfection
Hand and fingernail care: Appearance: clean, healthy, well cared-for, short fingernails, no nail varnish, no nail ornamentation
Injuries: Examples: Inflammation, cuts, skin cracks and grazes must be treated with hygienic, waterproof dressings!
Because they can transfer contamination, special care must be given to the hands!
for example, and can be transferred to foodstuffs by sneezing or coughing. They cause illnesses including diarrhea and vomiting.
Noroviruses: Transmission routes include uncooked foods such as salads. They cause diarrhea and vomiting.
Mold fungi: Can form carcinogenic toxins (mycotoxins) in spoiled foods.
In addition to the legislator (including through Regulation (EC) No. 852/2004 on the hygiene of foodstuffs), private law food safety standards (IFS, BRC etc.) also impose corresponding requirements in the hand hygiene area.
Extract from IFS Food Standard V 6.1: Requirement No. 3.4.7 – Hand hygiene installations shall fulfill at least the following requirements:
+ running potable water at a suitable temperature,
+ liquid soap,
+ suitable hand-drying equipment.
Requirement No. 3.4.8 – In areas in which easily perishable foods are handled, the following additional hand hygiene requirements shall be satisfied:
+ non-contact fittings,
+ hand disinfection,
+ adequate hygiene equipment,
+ instruction notices with hand hygiene rules / pictograms,
+ waste containers with a non-contact means to open them.
Requirement No. 3.4.9 – Based on a hazard analysis and an assessment of the associated risks, a program to monitor the effectiveness of hand hygiene shall be present.
Accordingly, regulations to monitor the success of cleaning shall also be defined, in addition to the purely technical fittings and equipment of washing stations. This should take place based on risk. Fully-baked products are certainly less “sensitive” than easily perishable baked products/snacks as far as the growth of microorganisms is concerned. The cleaning success of hand hygiene can only be monitored very poorly or not at all by visual inspection with the naked eye.
Nonetheless, hands, fingernails or even underarms that are obviously clean are certainly an indication. However, if a provable demonstration of successful hand hygiene is required, swab tests must be used to examine and evaluate the total bacteria count etc. in the laboratory.
A variety of disinfectants for surface disinfection or hand disinfection, as well as disinfectants against bacteria (bactericides), viruses (viricides), spores (sporicidal agents) or molds (fungicides) are available on the market. The Applied Hygiene Association (VAH) has published a list of disinfectant products that have been examined by accredited laboratories and independent assessors.
The area of adequate hygiene equipment also includes drying the hands. Disposable hand towels, or even cotton towels on rolls, are customary in the sector and are also accepted by auditors and food supervision authorities. Which system is used (Centerfeed, Tork, CWS cloth hand towel dispensers etc.) also depends on the operational circumstances as well as on procurement/operating costs. Restocking towels/rolls must be organized, handling the restocking/refilling must be simple and easy, etc., and so must the withdrawal of the towels (tear-off etc.). Hand-dryers (hot-air dryers) are used seldom or not at all.
Short-term wearing of disposable gloves when processing readily perishable foods can make sense. Bare hands are no less hygienic than gloves. Consequently, regular hand-washing and if necessary disinfecting the hands, and banning the wearing of jewelry, is preferable to wearing gloves in the bakery area (including sales). +++
Author
Dipl.-Ing. Sabine Botterbrodt
Portecta GmbH, E-Mail: botterbrodt@portecta.de, Website: www.portecta.de
According to Russian media, the Russian large-scale bakery SMAK plans to build a new production facility. The new plant will be built near Koltsovo near Ekaterinburg with construction planned to start in the summer of 2019. The 40,000 m² bakery is scheduled to go into operation in autumn 2021. The project costs are estimated at 3.6 billion roubles (around EUR 50 million). CEO Vladilen Fufarov reported to the media: "Over the last 18 years we have increased production by a factor of five and we deliver 100 tonnes of the products every day. The construction of the new plant will double the production volume as an absolute minimum." +++

Mid Europa Partners is to acquire a majority stake in the Croatian bakery chain Mlinar. Company founder Mato Mato Škojo will, according to the investor group, continue to have a stake in the company. The transaction is expected to close in the second quarter of 2019. Mlinar operates around 220 of its own stores and franchise stores in ten countries in Croatia and Slovenia. +++
Marché Mövenpick opened a new restaurant in the Lippo Mall Puri in Jakarta, Indonesia at the beginning of May. It is as usual for Marché, set up according to the marketplace concept. Visitors go from market stall to market stall to individually arrange their meal. The company reports, “In this
way people can enjoy a genuine European market feeling and Swiss hospitality”. Pizzas, pasta and European patisserie are among the products on offer. +++
USA:
According to the magazine Lebensmittel Zeitung, the US bakery chain Panera Bread has a new CEO. Niren Chaudhary is set to take over from Blaine Hurst, who will become Vice Chairman of the company's Supervisory Board. Chaudhary comes from the US donut chain Krispy Kreme, where he has been the Chief Operations Officer since 2017, according to the newspaper. Panera Bread was acquired by JAB Holdings of the Reimann family in 2017 for approximately $7.5 billion. According to LZ, Panera Bread currently operates 2,130 branches in 48 US states and Canada. Krispy Kreme has also belonged to JAB Holdings since 2016. +++
According to information from GTAI Germany Trade & Invest, production of bread and bakery products in the Ukraine fell by 4.8% in the first eleven months of 2018. Investments are now being made in the frozen bakery products segment. In spring 2018, Kulinichi (website: kulinichi.com) began construction of a plant near Kharkiv for EUR 50 million. Hlibinvest (website: hlibinvest.com.ua) is investing EUR 25 million in the construction of a plant near Kiev. The first expansion stage was commissioned at the end of November 2018. Half of the production is destined for export. +++
June 18-21, 2019
Tehran/Iran
iran bakery + confectionery www.iran-bakery.com
June 25-28, 2019
Nairobi/Kenya
Snack and Sweet Africa Expo www.snackandsweetafrica.com
June 27-28, 2019
Barcelona/Spain
SNACKEX
www.snackex.com
July 22-24, 2019
Tokyo/Japan
Patisserie & Boulangerie Japan 2019 www.bakery-expo.com/2019/en
September, 4-7, 2019
Riga/Latvia
Riga Food 2019
www.bt1.lv/rigafood/eng
September 7-11, 2019
Las Vegas/USA
IBIE – International Baking Industry Exposition www.ibie2019.com
September 21-24, 2019
Stuttgart/Germany
südback – Trade fair for the bakery and confectionery trades
www.messe-stuttgart.de/suedback/en
October 5-9, 2019
Cologne/Germany
Anuga 2019
(including Anuga Bread & Bakery) www.anuga.com
November 1-3, 2019
Birmingham/UK
Cake International - The Sugarcraft, Cake Decorating & Baking Show
www.cakeinternational.co.uk
November 16-19, 2019
Rimini/Italy
FoodNova –
Gluten Free Expo, Lactose Free Expo, Expo Veg and Ethnic Food Expo www.foodnova.eu



